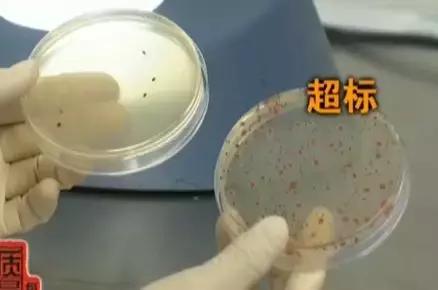
国内公认垃圾面膜曝光事件,央视曝光烂脸面膜名单

面膜这东西有涂抹式的、片儿状的、动物形状的、带金箔的,功能也有保湿、美白、除皱、抗老等等。

但是不瞒你说,不管噱头是啥,不靠谱的面膜倒挺多的。
在前段时间,登上主流媒体的面膜质量问题,就引起了很大的动静。

在视频里能看到,已经有不少买家的脸被毁了。
有的是只用了一次某品牌的面膜,脸上立马过敏,红肿起痘。

有的是直接在店家的店铺里评论,说自己的脸一直在发痒,有种火辣辣的灼烧感。

有的红肿发炎,脸上的痘痘都能连成片。

买家都在骂这家旗舰店卖假货,说自己好好的一张脸,现在却长满了疙瘩、*血丝红**,“这次脸算是毁了!”



气人的是,跟店家联系的时候,他们却像个没事儿人一样。
说他们家的面膜特别好用,都是植物系列的。

那如果过敏了怎么办?
他们的说法更玄幻,过敏是因为买的人属于过敏体质,跟他们的面膜没有任何关系

。

不愧是好评率100%的店铺,连甩锅的话术,都是一套一套的。
不过面膜在进行检测的时候,就现出原形了。
他们家一款主打“熊果苷”成分的面膜菌落超标84倍。

表面上看看起来干干净净的面膜,实际上已经脏到让人想吐了。
如果说只是一款面膜超标,也许是生产的时候没把控好,但这家公司,估计是以菌落超标为传统了吧。
因为另外三款面膜菌落同样超标,哪怕是最低的也超了26倍。

其他两个公司生产的假面膜更狠,一个是“婴国天使”面膜菌落超标了1000倍。

一个是“珀微”面膜菌落超标7200倍。

只要这些菌落超了标,有害病菌通过伤口进入皮肤,就有可能引起皮肤感染、损伤。
虽然这已经是几个月之前曝光的事儿了,当时都闹得都上了热搜。

可这并不是结束。
本以为商家的面膜出问题,就会马上下架,再上新另一款,可是人家连风头都不带避的,该卖还是卖。
刚刚小亚手动查了一下,发现之前有问题的面膜,在网上卖的销量还都挺好。

两款面膜都是一百多块钱六片,评论区有几百条好评,说是好用又补水。
仅有的一条负面评价,是一个女生说自己用了面膜长痘,结果被淹没在这些吹嘘的评论里。

不知道这次无辜上当的顾客又有多少。
那你说干脆不用面膜了,直接去美容院做护理总该行了吧。

千万不要把这些公司想得这么简单,一些面膜公司专门跟美容院合作。
直接往面膜里面兑能让人上瘾的“皮肤*片鸦**”,糖皮质激素。

这是国家早就明令禁止添加在化妆品里的东西。
听起来特别熟悉的“魔法奇迹之补养面膜”,跟另一款“静距离千颜万语面膜”就加了它。

只要一用上,刚开始感觉“效果”特别好。
脸上有*血丝红**或者敏感的,感觉用一下子就见效,没过多久脸上白白嫩嫩的,看起来年轻了好几岁。
实际上这只是表象,只要用的时间一长,脸上不是*疮痤**就是浮肿,最后皮肤变薄,越来越干,只能变成激素脸。

更严重的甚至能引起高血压高血脂、骨质疏松、导致胎儿畸形。
那些在网上声称自家面膜可以给孕妇用的,能想好后果再说吗?
所以大家在买面膜的时候,一定要挑选正规大厂家的产品。
这里是小亚大当家,我是小亚,感谢您的阅读。
另《毒液》、《邪不压正》资源已发布,有需要的朋友可添加同名微信公众号“小亚大当家”获取。